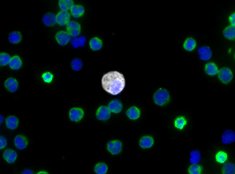

Technology Advantage
EPIC SCIENCES’ CTC ANALYSIS
Precision medicine initiatives in oncology focus on delivering targeted therapeutics to specific patient populations in which they will be most effective. Screening patients for sensitivity to these drugs has traditionally required translational researchers to retrospectively interrogate archived tumor biopsy samples for the presence of both protein and genomic markers. In many indications, the biopsy procedure is invasive, and biased due to both sampling error of the biopsy or evolution of the disease from therapeutic and immune selective pressure. Starting from a non-invasive peripheral blood draw, a liquid biopsy provides an alternative method to screen patients for markers of therapeutic sensitivity.

ANALYTICAL VALIDATION
The Epic Sciences CTC technology is a powerful rare cell detection and characterization platform aimed to ensure no cell left behind®. Since its incorporation, Epic Sciences has partnered with biopharma and academic institutions to provide a comprehensive view of cancer cell biology. Epic Sciences’ technology is currently being used in over 60 clinical trials and more than 150 collaboration projects. As of today, it has tested over 10,000 patient samples. The Epic Sciences CTC detection and characterization platform has been part of 50 peer reviewed papers, abstracts and posters which have been published and presented by leading academic, biotech and pharmaceutical collaborators.
Analytical validation in terms of assay performance, accuracy, linearity, specificity and precision of CTC enumeration was published in Werner et al, JCB 2015. An excerpt of data that highlights the performance of key parameters is shown below.

These are the analytical characteristics assessed to benchmark the performance of the Epic Sciences CTC detection and characterization platform. Varying concentrations of COLO-205 cell line cells (CLCs) were spiked into healthy donor blood, red blood cells were lysed, and 3 x 106 nucleated cells were deposited onto slides, ranging from 0-300 CLCs/slide. Slides were stained with a cocktail of CK, CD45 and DAPI antibodies. Assay accuracy, linearity, specificity and precision were determined as described in the methods. For each analysis, a “run” is comprised of three tests, with each test consisting of two replicate slides.
CTCs IDENTIFIED BY THE EPIC SCIENCES PLATFORM

Traditional CTCs would be confirmed by a pathologist as cancer cells. Traditional CTCs have an intact nucleus and express cytokeratins, which demonstrate epithelial origin and are negative for CD45, a white blood cell marker. They also have morphology consistent with cancer.
Cytokeratin negative (CK-) CTCs express neither cytokeratins nor CD45 but have an intact and irregular nucleus. They may be cancer stem cells or cells undergoing epithelial to mesenchymal transition (EMT). Epic Sciences has shown that this cell type has genomic aberrations and is prognostic for worse patient outcomes.

Apoptotic CTCs are cells that are undergoing apoptosis (cell death). Epic Sciences’ platform can identify nuclear fragmentation associated with this process. Measuring the ratio of traditional CTCs to apoptotic CTCs from baseline to therapy may provide clues to a treatment’s efficacy in targeting and killing cancer cells.

CTC Clusters consist of two or more individual circulating tumor cells bound together. The CTC cluster can be made up of traditional and/or CK- CTCs. In preclinical models, CTC clusters have demonstrated 50X more metastatic potential than single cells.
Learn more about the platform and see it in action: Review select publications, posters and webinars through our technical resources page.
UP TO DATE WITH EPIC SCIENCES
Read the Wall Street Journal article, Test Aids Prostate Cancer Treatment highlighting Epic Sciences AR-V7 liquid biopsy test being commercialized by Genomic Health.
